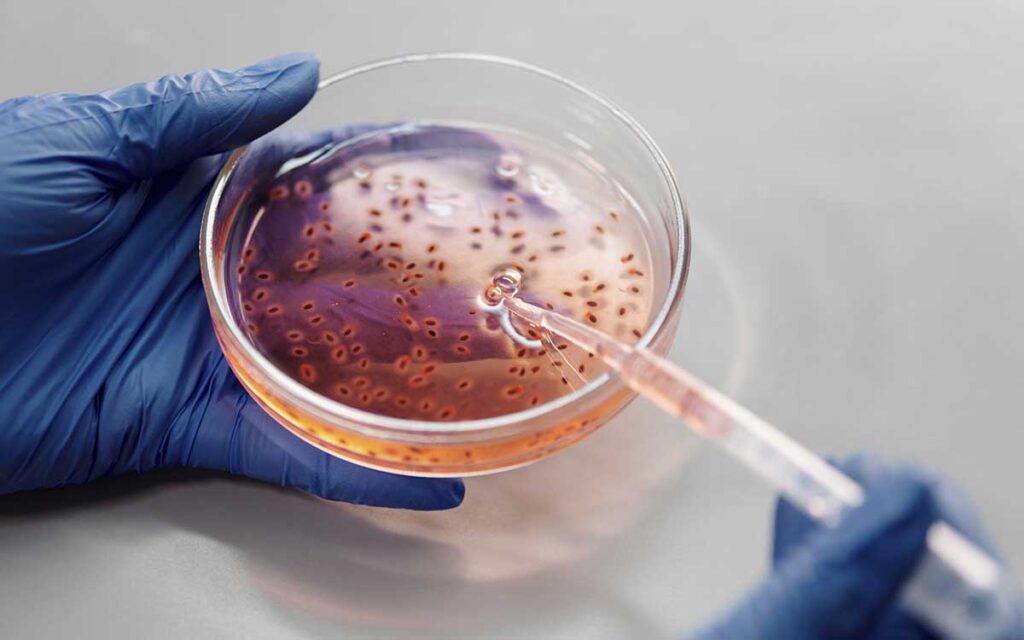

El Departamento de Salud de Florida (Estados Unidos) ha contabilizado en lo que va de año un total de 26 casos de personas infectadas por la peligrosa bacteria Vibrio vulnificus, conocida como la “devoradora de carne”, cinco de los cuales resultaron mortales.
La Vibrio vulnificus es una bacteria que se encuentra en el agua de mar cálida y salobre que puede ingresar al torrente sanguíneo través de cortes y rasguños recientes, indicó el Departamento de Salud de este estado sureño.
De acuerdo con el reporte, desde enero pasado la bacteria Vibrio vulnificus, que también se puede encontrar en mariscos crudos o poco cocidos, provocó la muerte de dos personas en el condado de Hillsborough.
Las tres muertes restantes provocadas por la rara bacteria tuvieron lugar en los condados de Polk, Pasco y Sarasota.
Todos estos condados, menos el de Polk, se encuentran situados en la costa floridana que da al Golfo de México.
Este año, según recuentos oficiales, se han reportado otras tres muertes en otros estados, incluida una en Nueva York y dos en Connecticut.
Las infecciones causadas por la Vibrio vulnificus son raras y más graves que la mayoría de las demás. Según los gubernamentales Centros para el Control y Prevención de Enfermedades (CDC), una de cada tres personas que se infecta con esta bacteria muere.
De acuerdo con la Clínica Cleveland, cada año se reportan entre 100 y 200 casos de infecciones provocadas por esta bacteria en Estados Unidos.
Si bien la mayoría de los que contraen vibrosis se recuperarán en aproximadamente tres días sin efectos a largo plazo, un pequeño porcentaje de los que la contraen requieren cuidados intensivos o incluso una amputación, dijeron los CDC.

El año pasado, Florida reportó 17 muertes y 74 casos, pero esos números fueron “anormalmente altos” debido a los impactos del huracán Ian, señaló en su informe el Departamento de Salud de Florida.
La Vibrio vulnificus afecta especialmente a ancianos o personas mayores con problemas en su sistema inmunológico y solo se combate con antibióticos.
Por todo ello, las autoridades sanitarias recomiendan a las personas con un sistema inmunológico débil utilizar sandalias o zapatillas en la playa, especialmente al subir a rocas.
Los médicos aconsejan, por su parte, abstenerse de comer marisco crudo, especialmente ostras, y no bañarse en el mar o agua salobre con heridas o cortes recientes en la piel para evitar toda posibilidad de contagio.
Con información Aristegui Noticias






